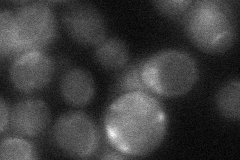
YDR085C
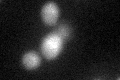
YDR085C
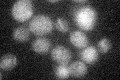
YDR085C

View description
Protein required for pheromone-induced projection (shmoo) formation; regulates septin architecture during mating; has an RVXF motif that mediates targeting of Glc7p to mating projections; interacts with Cdc12p
Localization:
Intensity:
Fold change:
Significance:
-
C’ GFP library in SD

below threshold15.8 -
N' NOP1pr-GFP in SD

punctate,bud neck39.8609 -
N' TEF2pr-mCherry in SD

punctate16.5204 -
N' NATIVEpr-GFP in SD

punctate17.5073 -
N' TEF2pr-VC and Cyto-VN in SD
below threshold26.7363 -
C’ GFP library in SD+DTT
cytosol17.471.1No -
C’ GFP library in SD+H2O2
cytosol14.790.93No -
C’ GFP library in Starvation Media

cytosol16.961.07No -
C’ GFP library on the background of Pup2-DaMP

below threshold -
C’ GFP library on the background of CCT mutant

below threshold16.68621.05595No
